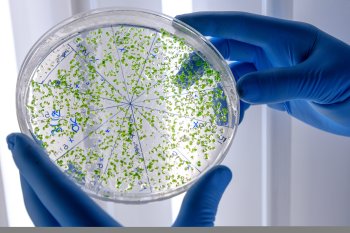

ROMANIA. STIRI. PRESA LOCALA:
Stiri :
Muntenia :
Prahova
:
Ploieşti
|
Câmpina
|
Sinaia
|
Azuga
|
Băicoi
|
Buşteni, Prahova
|
Comarnic
|
Mizil
|
Plopeni
|
Slănic Prahova
|
Urlaţi
|
Vălenii de Munte
Incendiu la un camion care transporta produse congelate şi băuturi: traficul rutier, blocat pe DN 1
Un incendiu a izbucnit, marţi seară, la un camion care transporta...
[StiripeSurse] 07/04/2026
[StiripeSurse] 07/04/2026
Rămase fără bijuterii după ce au crezut în „minuni”. Metoda prin care două femei din Prahova au păcălit victimele
Două femei reținute din Câmpina au fost acuzate de poliţişti...
[B1 Tv] 07/04/2026
[B1 Tv] 07/04/2026
Rămase fără bijuterii după ce au crezut în „minuni”. Metoda prin care două femei din Prahova au păcălit victimele
Două femei reținute din Câmpina au fost acuzate de poliţişti...
[B1tv] 07/04/2026
[B1tv] 07/04/2026
Incendiu puternic în Brebu Megieşesc. Pompierii din Prahova intervin
Pompierii din judeţul Prahova intervin, marţi, pentru stingerea unui...
[StiripeSurse] 07/04/2026
[StiripeSurse] 07/04/2026
Un tânăr de 22 de ani din Prahova și-a ucis în bătaie propriul copil, în vârstă de doar 2 luni
Un caz cutremurător zguduie comunitatea din Ploiești, după ce un...
[DCNews] 07/04/2026
[DCNews] 07/04/2026
Un tânăr de 22 de ani din Prahova și-a ucis în bătaie propriul copil, în vârstă de doar 2 luni
Un caz cutremurător zguduie comunitatea din Ploiești, după ce un...
[DCNews] 07/04/2026
[DCNews] 07/04/2026
Un tânăr de 22 de ani din Prahova și-a ucis în bătaie propriul copil, în vârstă de doar 2 luni
Un caz cutremurător zguduie comunitatea din Ploiești, după ce un...
[DCNews] 07/04/2026
[DCNews] 07/04/2026
Caz halucinant în Prahova! Un tată în vârstă de 22 de ani este suspectat că și-a ucis bebelușul de doar două luni. Motivul șocant pentru care ar fi făcut asta
Polițiștii din Prahova investighează circumstanțele în care a...
[WowBiz] 07/04/2026
[WowBiz] 07/04/2026
LPF-ul, impresionat de Știința! Trei „lei“ au prins echipa etapei a 3-a din play-off/play-out
Liga Profesionistă de Fotbal (LPF) a anunțat echipa etapei a 3-a...
[Gazeta de Sud] 07/04/2026
[Gazeta de Sud] 07/04/2026
Tată de 22 de ani, suspectat că şi-ar fi omorât bebeluşul de doar 2 luni. L-a scuturat pentru că plângea
Un caz grav este investigat de polițiștii din județul Prahova,...
[Observator] 07/04/2026
[Observator] 07/04/2026
Anchetă în Prahova după moartea suspectă a unui bebeluș de două luni. Suspectul principal este tatăl copilului
Este anchetă în Prahova după moartea unui copil de doar două luni....
[Adevarul] 07/04/2026
[Adevarul] 07/04/2026
Probleme la Spitalul de Pediatrie din Ploiești! Bacteria Pseudomoas Aeruginosa a fost descoperită în apa furnizată
Spitalul de Pediatrie din Ploieşti, cea mai mare unitate sanitară...
[WowBiz] 07/04/2026
[WowBiz] 07/04/2026
Tragedia de la Crevedia s-ar putea repeta tot lângă București. Localnicii din Clinceni au descoperit o stație de transfer GPL, cu zeci de cisterne, aproape de casele lor: „Se aud pompele și...
O comunitate din Clinceni, judeţul Ilfov, stă pe un butoi de pulbere...
[Gândul] 07/04/2026
[Gândul] 07/04/2026
Bacilul Piocianic, descoperit din nou în reţeaua de apă a Spitalului de Pediatrie din Ploieşti. Se vor limita internările
Spitalul de Pediatrie din Ploieşti, cea mai mare unitate sanitară...
[HotNews] 06/04/2026
[HotNews] 06/04/2026
Incendiu la o clădire dezafectată a fostului Institut de Petrol și Gaze din Câmpina
Pompierii prahoveni intervin pentru stingerea unui incendiu izbucnit...
[Mediafax] 06/04/2026
[Mediafax] 06/04/2026
Raisa Enachi (Neafiliat): De la promisiuni la poluare, realitatea din teren contrazice Ministerul Mediului
În România, poluarea apelor nu mai este o excepție, ci un tipar....
[Amos News] 06/04/2026
[Amos News] 06/04/2026
Incident grav în Pitești. Un copil a căzut de la etajul 4. Medicii îl resuscitează
Scene șocante la în Argeș. Luni, în jurul prânzului, un copil s-a...
[Gândul] 06/04/2026
[Gândul] 06/04/2026
Turismul în luna februarie 2026
În luna februarie 2026, comparativ cu luna februarie 2025, sosirile...
[Amos News] 06/04/2026
[Amos News] 06/04/2026
Percheziție cu bucluc. Ce au găsit polițiștii la cazările muncitorilor de la șantierul căii ferate Cluj-Oradea
Percheziție cu bucluc în Cluj-Napoca. În cursul zilei de 5 aprilie...
[Gândul] 05/04/2026
[Gândul] 05/04/2026
Noapte de panică în Prahova după ce o cisternă cu 30 de tone de GPL s-a răsturnat: "Am rămas aşa ţepeni"
Pericol uriaş într-o localitate din Prahova. Aproape 100 de oameni...
[Observator] 05/04/2026
[Observator] 05/04/2026
Peste 10.000 de oameni de lângă Ploiești, lăsați fără apă după o avarie la stația de tratare a apei ESZ Prahova
Compania Exploatare Sistem Zonal Prahova a anunțat, duminică...
[Libertatea] 05/04/2026
[Libertatea] 05/04/2026
Explozie în Galați, după utilizarea greșită a unei butelii. Ușa de la intrare a fost smulsă din perete
Neglijenţă periculoasă. Două explozii, în localităţi diferite,...
[Observator] 05/04/2026
[Observator] 05/04/2026
Cisternă cu GPL răsturnată pe DN1D, în Prahova. Localnicii au fost evacuați în miezul nopții
Accident extrem de grav, aseară, în Prahova! Un șofer, aflat la...
[Observator] 05/04/2026
[Observator] 05/04/2026
Populația a fost evacuată pe o rază de 1 km la Ciorani, județul Prahova: O cisternă cu GPL s-a răsturnat pe DN 1D (Foto) UPDATE Trafic blocat, a fost emis mesaj RO-Alert
O cisternă încărcată cu 30 de tone de gaz petrolier lichefiat...
[Spot] 04/04/2026
[Spot] 04/04/2026
Pericol major în Prahova: cisternă cu GPL răsturnată, zeci de oameni evacuați preventiv
Autoritățile au intervenit rapid și au decis evacuarea preventivă...
[Romania Libera] 04/04/2026
[Romania Libera] 04/04/2026
Prahova: O cisternă care transporta GPL s-a răsturnat. Populația a fost evacuată pe o rază de un kilometru. A fost emis RO-Alert
„Pompierii din cadrul ISU Prahova intervin pentru gestionarea unui...
[Mediafax] 04/04/2026
[Mediafax] 04/04/2026
Raed Arafat, declarații despre cisterna cu GPL răsturnată în Prahova: 'Evacuarea este necesară' / Intervenție complexă, cu roboți și echipe specializate
Șeful DSU Raed Arafat a oferit detalii despre intervenția de...
[StiripeSurse] 04/04/2026
[StiripeSurse] 04/04/2026
Zeci de persoane evacuate după ce o cisternă cu GPL s-a răsturnat pe DN1
Peste 70 de persoane au fost evacuate, sâmbătă seară, după ce o...
[Europa FM] 04/04/2026
[Europa FM] 04/04/2026
| Adăugarea sau scoaterea conținutului dvs | Contact
|
ZIAR.COM : știri libere | știri tv live și știri de ultima oră
Ziar.com indexează publicații diverse, ziare și reviste cu poziții diferite, existente independent online. Ideile și comentariile exprimate în aceste articole nu reflectează opiniile Ziar.com și nu pot fi imputate acestuia. Pentru orice informație complementară sau reclamație cu privire la conținut, consultați direct ziarele relevante – sursa este întotdeauna indicată, cu un link spre articolul de origină.
Publicare, realizare si gazduire web : DIRECTWAY. Toate drepturile rezervate, reproducerea interzisa - Copyright © 1996-2026 DIRECTWAY